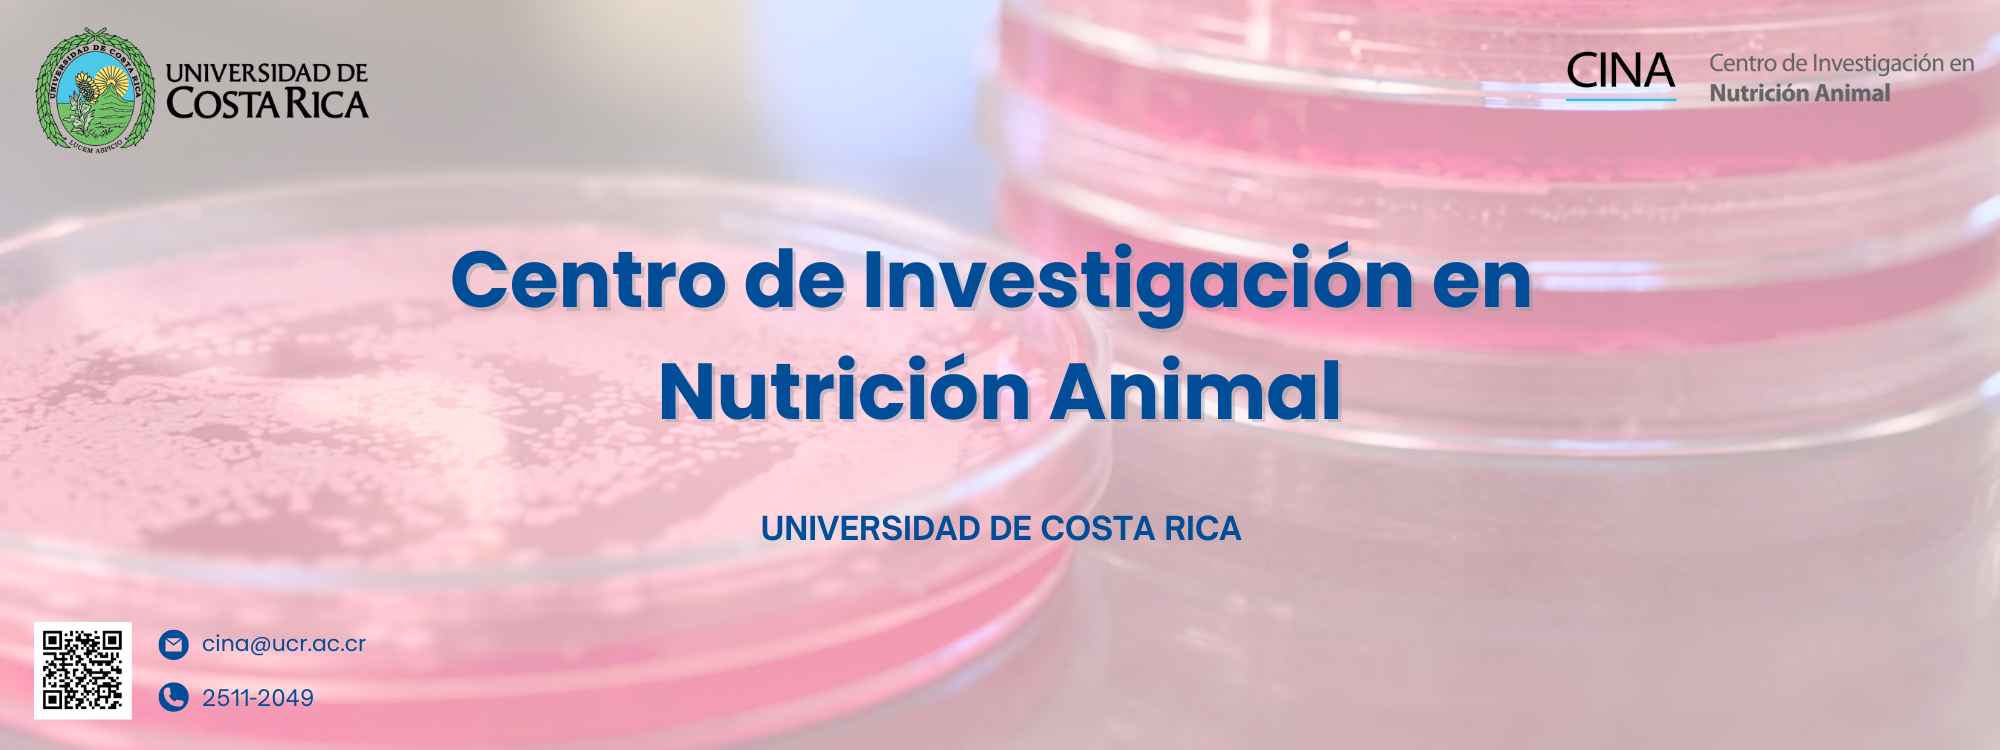

El Centro de Investigación en Nutrición Animal (CINA) es una unidad adscrita a la Vicerrectoría de Investigación de la Universidad de Costa Rica. Está conformado por un equipo de profesionales especializados en diversas áreas, enfocados en generar conocimiento en nutrición animal y garantizar la inocuidad de los alimentos. Además, desempeña un papel clave en el control de calidad de los alimentos destinados al consumo animal en Costa Rica.
El CINA brinda al sector de fabricantes de alimentos para animales, productores y al público en general, valiosa información sobre la composición nutricional de materias primas, alimentos balanceados, forrajes, suplementos y subproductos agrícolas, entre otros. Estos insumos son esenciales para la elaboración de dietas que consumen tanto animales en sistemas productivos como mascotas y otros animales bajo manejo especializado.
Además, el CINA actúa como el Laboratorio Oficial de Control de Calidad de Alimentos para Animales, conforme a la Ley de la República N.° 6883, "Ley para la Elaboración y el Expendio de los Alimentos para Animales", y su reglamento (Decreto 16899-MAG).
Seguí nuestras redes sociales
-
Aportar al sector pecuario los análisis de alimentos que requieren, ya sea por necesidades específicas o por la legislación nacional e internacional.
-
Desarrollar, en colaboración con la Dirección de Alimentos para Animales del Ministerio de Agricultura y Ganadería (DAA-MAG), las regulaciones pertinentes en el área de alimentación animal.
-
Contribuir a la educación del personal de las plantas de alimentos para animales en buenas prácticas de manufactura e inocuidad.
-
Procurar la satisfacción del cliente mediante la prestación de servicios de alta calidad.
-
Promover la formación de profesionales involucrados en el campo de la producción y nutrición animal.
-
Fortalecer la investigación y la transferencia de conocimientos hacia el sector pecuario.
-
Fomentar la nutrición adecuada de las diferentes especies de animales, con el objetivo de garantizar su salud y bienestar.

Enlaces de interés